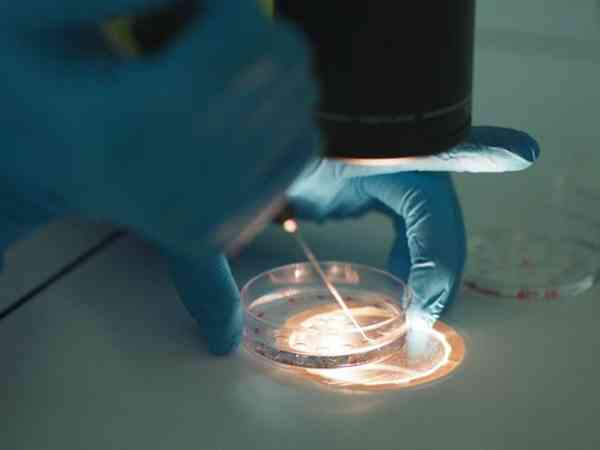

依使用者真實經歷、反饋整理中山大學附屬中山醫院生殖中心成功率資料參考,綜合疾病、方案、需求等多維度彙總中山人民醫院試管嬰兒專家擅長,同步更新中山人民醫院生殖醫生成功率實時排名,幫助更多人發現中山人民醫院試管嬰兒專家誰最好。

中山人民醫院試管成功率統計,不同年齡真實資料差距竟然這麼大
一般只有30歲以下且身體素質較好的患者在中山市人民醫院做試管一次成功率可以達到60%左右,正常情況下的患者一次成功率均在40%-45%左右,這個成功率在中山試管嬰兒醫院中也算是非常不錯的了。大家如果想要儘可能提高試管一次成功率,那就一定要趁自己年輕的時候去做試管,試管前也一定將身體狀態調整到最佳狀態。中山人民醫院試管成功率分析中山市人民醫院生殖中心開展不孕不育症的診治多年,目前已獲准開展夫精人工授...

百變小櫻
07-04
解析中山人民醫院試管費用明細,術前檢查的收費真不是最高的
據在中山市人民醫院做試管嬰兒的姐妹瞭解到,在該院生殖中心做一次試管費用一般都在2-4萬元不等,因為中山市人民醫院目前也只開展了常規體外受精-胚胎移植技術、卵胞漿內單精子顯微注射技術兩項試管嬰兒技術,而這兩項技術收費也都並不貴,一般第一代試管嬰兒費用就在2到3萬元左右,二代試管嬰兒費用就是3到4萬元左右。中山人民醫院試管費用術前檢查費用:我的術前檢查2498元,老公生殖彩超+術前檢查2777元,凍精...

寂寞吸血姬
07-02
中山人民醫院試管促排全過程,歷時10天該階段終於畢業
我是在中山人民醫院做的試管,月經第2天開始促排,然後預約週一建檔,做完b超定了拮抗劑方案,一般等男女體檢報告出來後去醫院建檔,建檔結束再定方案開醫囑,促排第三天排隊取抽血號,血值報告10點出來,lh2.2,fsh11.20,e2127,p0.329,lh比上個月低好多,fsh高好多,接著促排第四天、第五天...促排卵全過程歷時十天,該階段總算畢業了。開始促排模式啦2021.4.17,在中山人民醫院...

趙小米
07-02